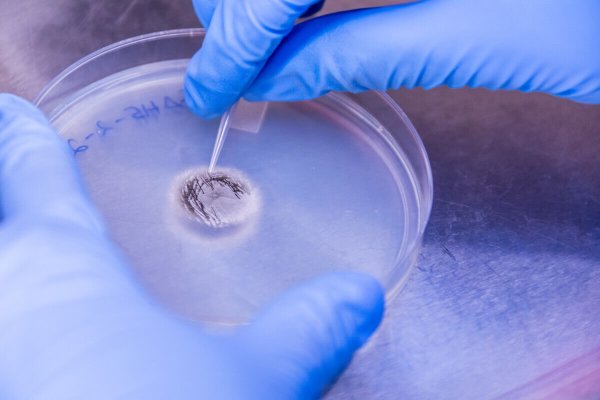

Chemistry
Create Satisfying Solutions
Shenandoah’s Bachelor of Science in Chemistry program prepares you for graduate studies and for a career in pharmacy, medicine, dentistry, molecular biology, environmental monitoring and control, research and development, teaching and more.
The chemistry program has given me the critical thinking skills that are needed to be successful in graduate school and as a pharmacist. It has allowed me to gain a necessary understanding of information that will be further developed and challenged in pharmacy school.”
Madison Meyers ’24 | Chemistry Major, Biology Minor
The chemistry program is committed to integrating both current and developing technology into our curriculum. Throughout the program you will also gain expertise with a variety of hands-on skills and methodologies in our laboratory courses.
You’ll have plenty of opportunities to participate in original research with our faculty, and you’ll learn how to approach problems using scientific methods. Through valuable hands-on experience with a variety of specialized laboratory equipment and instrumentation, you’ll sharpen your critical thinking and comprehension skills and gain scientific expertise in a supportive laboratory-based environment.
Shenandoah University’s College of Arts & Sciences is your direct connection to a classic, broad-based education to satisfy both your intellectual curiosity and career goals. With a 10:1 student-faculty ratio, small classes and individualized learning opportunities, we put students at the center of all our decisions and events.
We blend the liberal arts with pre-professional courses and hands-on learning to prepare you for careers in the natural sciences, the social sciences and the humanities. You’ll learn through small, engaging classes and relationships with faculty mentors; hone your skills to solve problems; and learn to use creativity and critical thinking to make informed decisions.
Shenandoah’s minor in Chemistry prepares you for graduate studies and for a career in pharmacy, medicine, dentistry, molecular biology, environmental monitoring and control, research and development, teaching and more.
Declaring a Minor
Shenandoah students work with their Academic Advisor to declare a minor. Academic Advisors will continue to work with students to ensure that they fulfill all of the requirements to complete the minor.
Incoming students should not indicate their intended minor on their Shenandoah application. Applications are for intended majors only.
The Career & Professional Development staff helps Shenandoah students search and apply for internships related to their major and career goals. Internships differentiate you as an applicant in your future job searches, provide hands on experience in your field, allow you to sample different career paths for your major, and help you find a specific position that fits your passion before graduation.
A Bachelor Of Science In Chemistry will prepare you for:
- Further studies in health-related occupations such as pharmacy, medicine, and dentistry
- Graduate study in chemistry and related fields (such as molecular biology and environmental science)
- Teaching in secondary schools
- Chemistry-related positions in industry and government, including quality control, environmental control, production supervision and research and development
Career and Salary Examples for Biology Majors:
- Senior Chemist: $81,801
- Research Scientist: $73,511
- Chemist: $55,447
- Research Chemist: $53,173
- Analytical Chemist: $49,057
- Quality Control (QC) Chemist: $53,292
- Laboratory Manager: $61,576
- High School Science Teacher: $31,085 – $66,384
- Clinical Research Associate (CRA): $38,630 – $87,505
Career & Professional Development provides a comprehensive range of services and resources to assist Shenandoah students in their career search. Services offered include resume and cover letter building, mock interviews, and professional dining etiquette workshops.
Throughout the program you will also gain expertise with a variety of hands-on skills and methodologies in our laboratory courses.
You’ll have plenty of opportunities to participate in original research with our faculty, and you’ll learn how to approach problems using scientific methods. Through valuable hands-on experience with a variety of specialized laboratory equipment and instrumentation, you’ll sharpen your critical thinking and comprehension skills and gain scientific expertise in a supportive laboratory-based environment.
Courses Required For The Chemistry Major
- CHEM 121 General Chemistry I (4 credits)
- CHEM 122 General Chemistry II (4 credits)
- CHEM 211 Analytical Chemistry (4 credits)
- CHEM 301 Organic Chemistry I (4 credits)
- CHEM 302 Organic Chemistry II (4 credits)
- CHEM 317 Inorganic Chemistry (4 credits)
- CHEM 321 Physical Chemistry I (4 credits)
- CHEM 322 Physical Chemistry II (4 credits)
- CHEM 331 Biochemistry I (4 credits)
- CHEM 332 Biochemistry II (4 credits)
- CHEM 491 Research Seminar (2 credits)
- CHEM 492 Research Seminar (2 credits)
- MATH 201 Calculus and Analytic Geometry I (5 credits)
- PHYS 111 College Physics I (4 credits) or PHYS 121 General Physics I (4 credits)
Total: 53 credits
Chemistry majors are strongly encouraged to take the following courses to complement their program:
- CHEM 311 Instrumental Analysis (4 credits)
- CHEM 420 Advanced Synthesis and Analysis (3 credits)
- MATH 202 Calculus and Analytic Geometry II (5 credits)
- PHYS 112 College Physics II (4 credits) or PHYS 122 General Physics II (4 credits)
Learning support services are available to all students in every course at Shenandoah. Free peer tutoring with a student who has previously succeeded in the course is available for any course across the university. The Writing Center is available for every stage of the writing process from thesis development to proofreading and bibliography assistance. The Math Enrichment Center is available for math and science assistance. Professors and Academic Advisors across the university also have office hours and open door policies to ensure Shenandoah students succeed academically.
Learn about Shenandoah’s Chemistry education programs:
The Honors Program is a multidisciplinary Honors Program for students who are curious, creative, self-motivated, and eager to engage in their education and community.
Not only do Honors Program students partake in honors courses that emphasize collaboration, service, and communication, but they will also have the opportunity to develop aspects of the program based on their own interests and goals. By participating in the Honors Program you will acquire the tools, knowledge and experiences necessary to make meaningful contributions to your community – whether it be globally, locally, or specific to your life’s work. You will have access to unique courses, exciting experiences and a community of peers and faculty who never stop asking questions and striving for excellence.
Shenandoah University works on rolling admissions and accepts applications throughout the year. Applications are reviewed individually and holistically.
Submit your application, review required admission materials, and find our admissions standards.
The Pre-Health Program is designed to help guide students develop as competitive applicants to graduate schools that match their desired profession and their academic and pre-professional profile.
Pre-Health Advising at Shenandoah University consists of in-person advising sessions either in a group or individual setting that seek to provide guidance to students interested in pursuing a career in the health professions.
Pre-Health Students follow one of these tracks at Shenandoah:
Make studying abroad the highlight of your college experience! Whether you go for a year, a semester, or just a few weeks. You will never forget learning in another culture! The Center for International Programs is here to help you plan your study abroad experience. Start your planning early to ensure the courses you complete abroad count toward your degree and you graduate on time.
Global Experiential Learning (GEL) Program
The Global Experiential Learning (GEL) Program offers Shenandoah students a short-term, faculty-led, study-abroad experience for academic credit. These short-term, credit-bearing, faculty-led programs are offered winter break, spring break, and during the summer. If a course is not within your major, it might be used as an elective.
Study Abroad
Shenandoah University is a member of the International Student Exchange Program (ISEP), a global network of 300 universities. This partnership allows students to study for a full semester or year at other member campuses abroad. By working closely with their academic advisors and the study abroad advisor, students can take classes taught in English abroad while receiving Shenandoah credit.
Shenandoah University also maintains direct partnerships with several universities around the world. These relationships allow students from SU to study abroad as exchange students and students from these universities to study at SU. All partner universities offer courses taught in English.
Imagine participating in interesting conversations led by engaging professors who’ve already done what you dream of doing. You’ll be in a small class — the average class size is approximately 12 students — with professors who know your name, care about your success and provide advice as you pursue your academic and career goals.
Meet Brett Kite, Department Chair & Assistant Professor of Chemistry
Spotlights

Alumna Returns As Assistant Professor
Dr. Kathleen Lasick Wants to Provide Students With A Shenandoah Experience as Supportive as Her Own
Research Keeps Shenandoah University Students Buzzing Over the Summer
Projects Venture Into Innovative Territory
Alumni Successes

Alumna Returns As Assistant Professor
Dr. Kathleen Lasick Wants to Provide Students With A Shenandoah Experience as Supportive as Her Own


